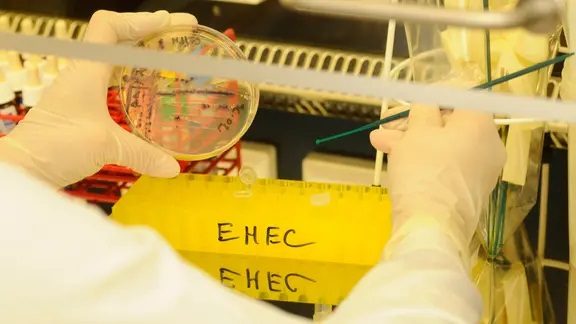

ألمانيا : تسجيل إصابات ببكتيريا خطيرة في هذا الولاية .. و دعوة لتسكيل فريق إدارة أزمات
أعلنت السلطات الصحية في مكلنبورغ-فوربومرن عن تسجيل 31 إصابة ببكتيريا EHEC، بينها 12 حالة خطيرة أدت إلى انحلال الدم اليوريمي وتستلزم غسيلاً كلوياً وإقامة طويلة في المستشفى.
وأكد مكتب الصحة تسجيل خمس إصابات جديدة لأطفال، فيما لا يزال مصدر العدوى مجهولًا رغم مشاركة معهد “روبرت كوخ” في التحقيقات التي تركز على العادات الغذائية والتواصل مع الحيوانات.
حالياً يتلقى 19 مصاباً العلاج في المستشفى وحالتهم مستقرة.
في المقابل، دعا “الحزب الديمقراطي المسيحي” إلى تشكيل فريق لإدارة الأزمات قبل عودة المدارس.
وفي الوقت نفسه، سحبت إحدى شركات الأغذية الألمانية دفعة من البصل المستورد الملوث ببكتيريا EHEC، دون وجود دليل مباشر على صلته بالتفشي الحالي.